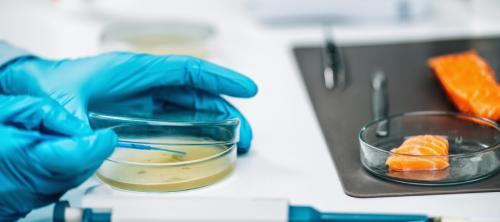
listeria

Calidad del aire en cocinas comerciales, ¿cómo mejorarla?
Enviado por editora el Jue, 04/02/2026 - 01:08En las cocinas comerciales, ya sean de restaurantes, bares o restauración colectiva, se llevan diariamente a cabo dos actividades con un elevado potencial de emitir contaminantes en el aire interior: cocinar y limpiar. Un estudio realizado en Italia evalua la calidad del aire en las cocinas de 15 restaurantes de ese país y formula recomendaciones para mejorar el aire que respira el personal de cocina.